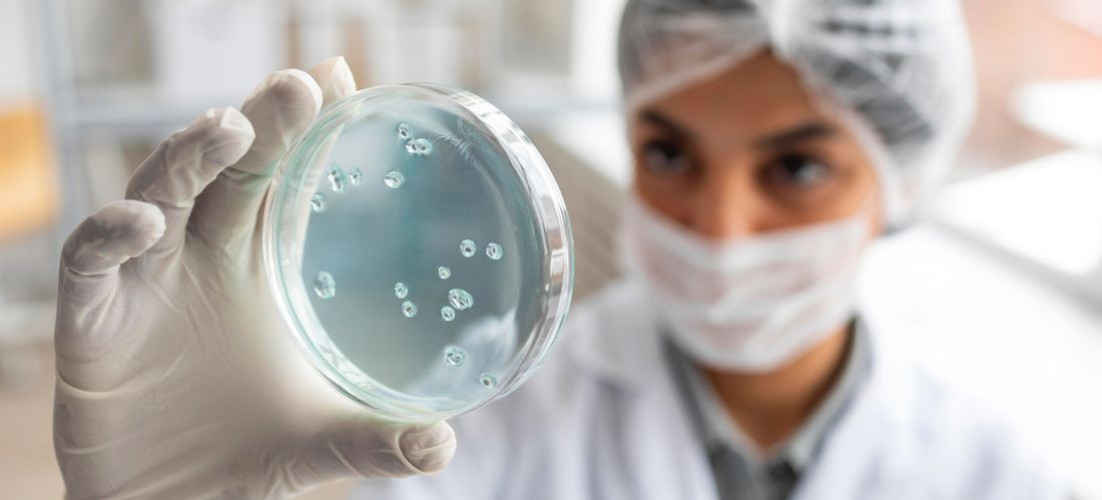
Mikrobiolog

Mikrobiolog
Mikrobiolog zajmuje się badaniem drobnoustrojów i środowiska, w którym występują: ludzi, zwierząt, roślin. Najważniejszym zakresem jego zainteresowania są zjawiska i procesy zachodzą w danej z tych grup.
Czym zajmuje się mikrobiolog?
Mikrobiolog to specjalista zajmujący się badaniem mikroorganizmów – bakterii, wirusów, grzybów, glonów czy pierwotniaków – oraz ich wpływu na człowieka, zwierzęta, rośliny i środowisko. To zawód z pogranicza biologii, medycyny, biotechnologii i chemii, który odgrywa ogromne znaczenie w ochronie zdrowia, przemyśle i badaniach naukowych.
Mikrobiolog:
- prowadzi badania laboratoryjne nad mikroorganizmami,
- analizuje ich wpływ na organizmy żywe i procesy środowiskowe,
- opracowuje metody diagnostyczne i testy wykrywania patogenów,
- wspiera rozwój leków, szczepionek, antybiotyków i probiotyków,
- pracuje nad procesami biotechnologicznymi (np. produkcją żywności, oczyszczaniem ścieków, biopaliwami),
- monitoruje bezpieczeństwo sanitarne w przemyśle spożywczym, farmaceutycznym czy kosmetycznym.
Mikrobiolog może się specjalizować w jednej z następujących dziedzin:
- mikrobiologia ogólna - zajmuje się charakterystyką ogólnych, najbardziej podstawowych pojęć z dziedziny mikrobiologii: fizjologia, anatomia, rozmnażanie, środowisko życia drobnoustrojów, wpływ drobnoustrojów na ich środowisko życia i inne organizmy
- mikrobiologia szczegółowa - zajmuje się aktualizowaniem danych o osiągnięcia najnowszych badań systematycznych, realizuje szczegółowe badanie mikroorganizmów poszczególnych gatunków, prowadzi systematykę drobnoustrojów oraz charakterystykę poszczególnych taksonów klasyfikacji:
- mikrobiologia przemysłowa - związana jest z biotechnologią, dotyczący możliwości wykorzystania drobnoustrojów do procesów przemysłowych (przemysł: chemiczny, farmaceutyczny, kosmetyczny, piekarniczy, browarniczy, winiarski oraz oczyszczanie ścieków). Dziedzina ta zajmuje się wykrywaniem, badaniem i dostosowaniem do przemysłowego wykorzystania metabolicznych procesów, właściwości drobnoustrojów.
- mikrobiologia środowiskowa - dotyczy wpływu drobnoustrojów na ożywione i nieożywione elementy środowiska oraz wpływu tych elementów na mikroorganizmy. Zajmuje się badaniem środowisk występowania drobnoustrojów, również tych najbardziej wymagających (słone i gorące jeziora USA, głębiny oceaniczne, pustynie itp.) i opisywaniem właściwości, które umożliwiają im bytowanie w tych często niesprzyjających warunkach. Praktycznie mikrobiologia środowiskowa dostarcza wiadomości jak wykorzystywać drobnoustroje do oczyszczania ścieków, odradzania terenów "jałowych"/ubogich biologicznie
- mikrobiologia lekarska - dziedzina związana z medycyną, zajmuje się badaniem mikroorganizmów pod względem ich wpływu na organizmy żywe, człowieka, zwierzęta i rośliny. Opisuje przebieg chorób, sposoby leczenia, profilaktyki.
- mikrobiologia weterynaryjna - zajmuje się badaniem oddziaływania drobnoustrojów chorobotwórczych na zwierzęta
- mikrobiologia sanitarna - sposoby rozprzestrzeniania się drobnoustrojów patogennych dla roślin
- mikrobiologia gleby - drobnoustroje w środowisku glebowym.
Jak zostać mikrobiologiem?
Osoba, która chce pracować w zawodzie mikrobiologa, musi ukończyć studia wyższe, najlepiej na kierunkach Mikrobiologia, Biologia. W przypadku mikrobiologii lekarskiej, trzeba ukończyć kierunek lekarski ze specjalizacją mikrobiologiczną.
Mikrobiolog musi być osobą pełna pasji wiedzy, dobrze zorganizowaną, dokładnie i sumiennie wykonywać powierzone mu zadania, aby przebadany materiał był w pełni sprawdzony. Jest to także zawód, w którym wymaga się pomysłowości i kreatywności w poszukiwaniu nowych zastosowań dla badanych organizmów.
Gdzie do pracy?
Mikrobiolog powinien szukać zatrudnienia w laboratoriach, instytucjach i ośrodkach badawczych, na uczelniach (to one dają bardzo dobre warunki do pracy naukowej i badawczej) czy w komercyjnych przedsiębiorstwach, które specjalizują się w tej dziedzinie. Specjaliści z tej dziedziny pracują w jednostkach kontrolno-pomiarowych, określonych działach firm przemysłu spożywczego, farmaceutycznego, kosmetycznego a także instytucjach z obszaru biologii medycznej, ochrony środowiska czy ochrony zdrowia.
Zarobki mikrobiologów
Według portalu wynagrodzenia.pl mediana miesięczna dla mikrobiologa wynosi 6 500 zł brutto (ok. 4 761 zł netto). Połowa osób zarabia w przedziale 5 860 - 7 530 zł brutto.
Na wysokość zarobków wpływ mają takie czynniki, jak doświadczenie zawodowe – specjaliści osiągają wyższe zarobki, zwłaszcza w R&D czy biotechnologii, rodzaj laboratorium lub branża – sektor farmaceutyczny i biotechnologiczny płaci więcej niż diagnostyka medyczna lub instytucje edukacyjne, ale też lokalizacja – wyższe wynagrodzenia są w dużych aglomeracjach, takich jak Warszawa, Kraków czy Wrocław. Znaczenie ma również wielkość firmy – oferują one wyższe pensje i dodatkowe benefity.
***
Interesują Cię studia biologiczno-przyrodnicze?
Poznaj kierunki ścisłe.
Nie wiesz, w jakim mieście studiować? - wybierz swój ośrodek akademicki.
Wyszukiwarka uczelni, kierunków, typów studiów ułatwi decyzje wszystkim niezdecydowanym kandydatom.
Wybiegaj w przyszłość, zaplanuj Studia podyplomowe.
Fot. Freepik
Powiązane zawody

Biochemik

Biotechnolog

Chemik

Diagnosta laboratoryjny

Epidemiolog

Genetyk

Inspektor ochrony środowiska



























































































































































